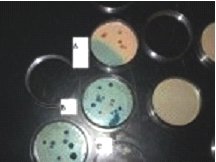

*Can You Be More Advanced About Preparedness Issues??*
Do you have the motivation and desire to be more advanced than the "Average Prepper" when it comes to Preparedness issues? Are you tired of people with the "Back Pack Survivalist" mentality? (We're talking about the people who've never actually tried to live for 5 days using only the contents of their bag, yet they're convinced that they can do it... obviously it's so easy that they don't even need to practice the skill!)
Are you tired of trying a project or product you saw online, only to find out it doesn't work? Are you tired of dealing with flame wars, racists, militants, zealots, BullS}{!t, egotists, and bigots with "personality disorders"? Would you like your family to be more involved in preparedness? (Hint: Your spouse is far more likely to become interested in preparedness topics if they aren't frightened by the forum member wearing a necklace of human ears)
Do you have the feeling that there is much more that you should be able to do to protect your family through any disaster?
Maybe you want to be able to run your home from alternate power indefinitely?


Do you know what the experts know about Pandemics and protection equipment? Do you know why you need a positive pressure of filtered air in your home during some disasters, and how to do it? Do you know what protection equipment works, and more importantly, what doesn't?

Do you know about Radiation, Radiation Equipment, EMP, and (again) what Does and Doesn't work?



Is your idea of "water storage", 500 gallons or more, connected to your home's plumbing?

Do you want your home to have a Layered Security System, accessible by you from anywhere? Can you control the lights, climate, etc, in your home while you're away? Is your home intelligent enough to control the lights and climate itself, and to notify you about problems? Can your home make an intruder want to leave Right Now? Of course you could do all of that, you simply need to learn how.



Can you see what's going on inside your house, before you go inside?

Do you know how to get a Bird's Eye View of your area?

Do you have a Saferoom or Underground Shelter?



Can you live like you do right now during and after a major disaster? Rubies can and have, with no outside help. When outside help is needed do you have group-mates that will help you, even before the disaster has stopped?



Can you feed you family for a year with No outside help? Do you know why your storage foods should be the same food you eat every day? Can you grow food in an efficient manner outdoors or indoors... all year 'round? Do you know why you can't depend on "Hunting" during a disaster?



Do you know the Myths commonly regarded as "Facts" about your vehicle? Will EMP really disable a modern vehicle? Can you protect your modern vehicle from EMP?

Does a product really do what it claims to do? Or is it hype? We Test it to find out before we use it!


How much heat does your Special-Purpose-Built House actually accumulate and store from just the sun in the winter?

Will that Concrete Shelter roof really hold the amount of dirt you're planning to put on top of it?


All this and much more is common among the members of the Rubicon area. Our motto is "Facta Non Verba" (Deeds, Not Words), and we test everything we do... We have access to labs and special equipment that most people don't have access to. Many of our members are business owners, some of those businesses happen to be certified labs of one type or another; we have members that work for private labs and can use them to test preparedness issues. "Lab testing" is just one example of how some of our members have found they can help the others... But those other members have their own unique skills and/or resources that they use to help the Lab Techs when needed. We've seen the owner of a private lab offer to test the quality of another member's well water for free when he voiced concerns about it... The next weekend the lab owner's wife said a farrier had stopped by earlier and put new shoes on her "hard-to-shoe horse"... Yup, the owner of the well is a farrier... We all use our skills to help each other whenever possible.
We don't compare ourselves to "sheeple", or "Survivalists", or even other Preppers, we compare ourselves to each other since we know our information is proven. We test, we question, we have the experts that have "Been there, done that" and can prove it. We don't say "I think", or "everyone knows", or "It seems logical that _____"... We just test and Prove everything that we can.
Preparedness is about much more than hunkering down during a disaster, and then scraping out a subsistence level existence afterward... it's about living before/during/after a disaster. Living as closely as possible to how you live right now.. it can be done, We do it routinely. Our members have lived through many disasters without missing a meal.
But it takes Work, Time, Effort, Money and Motivation. Rubies don't just stop by the forum to "Window Shop" and look at the cool toys other Rubies have, Rubies work to make their homesteads (and lives) as self sufficient as possible. They don't just "Dream", they "Do". They don't BS, they show each other how they have done a project, step by step.. and then they help other Rubies obtain the same thing through advice, group buys with discounts, alternate materials and methods, etc. Many of our members have very modest incomes, but we apply our income in a more efficient manner to make it stretch further for preparedness purposes.
Have you got the will and motivation to go further, and do more, than the "Average Prepper"? Rubicon Members do it every-single-day. What could you do for your fellow Rubicon members? Membership Info.
The Rubicon
www.alpharubicon.com
All materials at this site not otherwise credited are Copyright © 1996 - 2010 Trip Williams. All rights reserved. May be reproduced for personal use only. Use of any material contained herein is subject to stated terms or written permission.